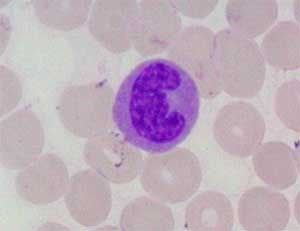
Resultado de imagem para monócito

Biologia dos tecidos: Sangue
- 30 de nov. de 2017
- 1 min de leitura
Atualizado: 7 de jul. de 2020
O sangue é uma solução composta pelo plasma e elementos figurados. Os elementos figurados são células que podem ser hemácias, leucócitos e plaquetas. Essas células são produzidas na medula óssea vermelha (=tecido hematocitopoiético), em um processo denominado hematocitopoiese. A célula hematocitopoiética produz células linfoídes (geralmente, células afetadas quando uma criança tem leucemia) e células mielóídes (células afetadas em caso de leucemia em adultos).
PLASMA
90% – Água; 10% – proteínas (albumina, imunoglobulina, fibrogênio, protombina… = 7%), compostos orgânicos (=2,1%) e sais minerais (=0,9%).
CÉLULAS
Hemácias: não são consideradas células verdadeiras pois são anucleadas. Possui forma bicôncava e tem vida útil de 120 dias (após sua morte, é levada para o baço). Sua produção, que ocorre na medula óssea, é estimulada pela eritoproteína que é formada no rim. Flexíveis, transportam oxigênio (O2) e dióxido de carbono (CO2).
Leucócitos: realizam a defesa do organismo. Podem ser granulócitos (específicos) como os neutrófilos, eosinófilos e basófilos, ou agranulócitos (não apresentam granulos específicos) como os linfócitos e os monócitos.
Tipos de leucócitos:
• Neutrófilo: -Polimorfonuclear (núcleo com vários lóbulos);
-Fagocita bactérias;
• Eosinófilo: -Bilobulado (núcleo com 2 lóbulos);
-Fagocita complexo antígeno;
Basófilo: -Relacionados com processos alérgicos;
-Apresenta granulos de histamina e heparina;
Linfócito: -T= resposta imunológica celular (3 tipos: CD4 ou helper, supressor e citóxico);
-B= resposta imunológica humoral (no conjuntivo se torma plasmócito);
-Falta causa leucopenia;
-Excesso causa leucocitose;
Monócito: -Defesa;
-Maior que as outras células;
-Núcleo em formato de rim/feto;
Plaquetas: auxilia na homeostasia (equilibrio), coagulação e se originam dos megacariócitos da medula.

Referência:
Aulas da Professora Milene Galhardo – Universidade de Taubaté

Comentários